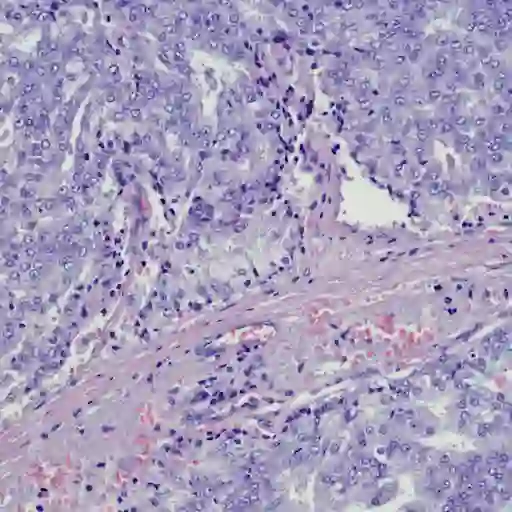

神话和事实对良性前列腺增生
不,这并不意味着你会得到前列腺癌。是的,它可以是一个真正的痛苦。我们的专家在BPH澄清。
学习你有良性前列腺增生(BPH),或者一个前列腺肿大,可以令人不安。条件是,顾名思义,癌变,但是它仍然可能造成不舒服的症状,影响你的生活质量。你可能会担心你的诊断和问题,如:我在更高的患前列腺癌的风险?良性前列腺增生会影响我的性健康?为了解决这些问题,我们请我们的专家将神话对良性前列腺增生的事实。
事实:BPH非常常见
“随着男性年龄的增长,他们的前列腺生长的自然发展,“狮子座r . Doumanian解释说,医学博士,泌尿科医生在南加州大学Keck医学在洛杉矶,CA,将近一半的男人51岁和60岁之间的良性前列腺增生的经验,根据美国国家卫生研究院(NIH)。地理:前列腺位于膀胱和尿道周围附近,地铁通过你的阴茎,把尿液从膀胱。这通常核桃大小的腺体扩张时,会导致症状尿频,排尿困难,无法空膀胱。

神话:所有例BPH需要治疗
一些男性前列腺肥大没有问题;其他症状可能轻微以至于他们不需要治疗。“良性前列腺增生可以无症状或症状严重程度和范围,”解释了阿明Sedaghat Herati,医学博士在巴尔的摩的约翰霍普金斯医学院泌尿科医师,医学博士,你的医生可能不会推荐的药物或治疗,除非你表达你的症状是麻烦的,Doumanian博士解释道。常见的良性前列腺增生的投诉包括在夜间醒来小便,增加紧迫感,弱流,流开始和困难。
事实:良性前列腺增生会导致恼人的症状
的症状良性前列腺增生可以frustrating-especially不可预知的冲动。这些麻烦可以带来的痛苦形式的睡眠中断,突然停站在你早上上班,和其他less-than-convenient并发症。“男人经常在办公室因为他们恼火20次在半夜醒来小便,或他们的配偶越来越恼火,“Doumanian博士说。
神话:你只需要接受前列腺肥大的症状
如果你的前列腺肥大症状并不严重,但他们仍然分散你,你有选择治疗。“虽然没有人死于漏尿,紧迫感,或频率,这是一个生活质量问题,“Doumanian博士说。值得庆幸的是,大量的治疗来帮助管理存在泌尿问题与良性前列腺增生、口服药物和手术治疗,梅奥诊所。最常见的手术治疗良性前列腺增生经尿道前列腺切除术(TURP),通常是无创或微创门诊手术。
事实:良性前列腺增生会导致其他严重的问题
对有些人而言,良性前列腺增生会导致并发症,需要治疗。例如,前列腺肥大可能引起尿路感染(UTI)或膀胱结石,,如果不及时治疗,会导致严重的问题,象肾损伤或膀胱损伤,根据美国国立卫生研究院。在某些情况下,前列腺肥大可能伤害你的膀胱功能随着时间的推移,你的膀胱已经难以正常运转工作紧密的前列腺,Herati博士说。但随着及时诊断和治疗,膀胱功能可以被保留下来。

神话:你的前列腺,越大越更多症状
大小真的不是万能的。“有大前列腺引起任何问题和小的,导致很多问题,”Doumanian博士说。“大前列腺并不意味着你会有问题,和一个更小的前列腺并不意味着你不需要治疗。“这是发生了什么内部影响良性前列腺增生前列腺的症状,而不是规模。“如果我感觉到你的前列腺直肠考试,感觉大在外面,这并不意味着必然发生阻塞在里面。”
事实:其他条件可能模仿BPH
如果你处理泌尿问题,不要以为这是良性前列腺增生。“我见过许多30年代和40年代的男性有条件称为盆底功能障碍,可以模仿BPH,“Herati博士说。盆底功能障碍的症状包括尿症状,盆腔疼痛、性功能障碍。如果你正在经历疼痛等问题的阴茎或会阴区域,或者你有困难维持勃起,告诉你的医生你可以得到适当的治疗。

事实:前列腺肥大不等于癌症
前列腺肥大不表明你有癌症前列腺或膀胱良性的条件。也就是说,一些前列腺癌和膀胱癌的症状可能类似于良性前列腺增生的症状。你应该马上检查医生如果你无法小便,你有痛苦,频繁,迫切需要小便,有发烧和发冷,你有巨大的痛苦在你的腹部和尿路低,或者你看到血液在你的尿液。

底线
不管你的前列腺肥大症状的严重程度,治疗选择如果你想要他们。轻微的麻烦是什么一个人可以为另一个构成一个大问题,所以如果你需要一些安慰,让你的医生知道。你的初级保健医生可能会问你的问题你的症状,然后请您留意一个泌尿科医生想出一个治疗计划,Herati博士说。“你不必把你的症状让old-there干预措施可以帮助你,”Doumanian博士说。
BPH信息:国家健康研究所。(2014)“前列腺肿大(良性前列腺增生)。”https://www.niddk.nih.gov/health-information/urologic-diseases/prostate-problems/prostate-enlargement-benign-prostatic-hyperplasia治疗
泌尿道感染的并发症:梅奥诊所。(2022)“尿路感染(UTI)。”https://www.mayoclinic.org/diseases - conditions/urinary束- infection/symptoms causes/syc - 20353447
良性前列腺增生和性功能障碍:哈佛健康。(2021)“性和前列腺:克服勃起功能障碍当你有前列腺疾病。”https://www.health.harvard.edu/blog/sex——————前列腺-克服勃起功能障碍——当——你——-前列腺疾病- 20090331100








